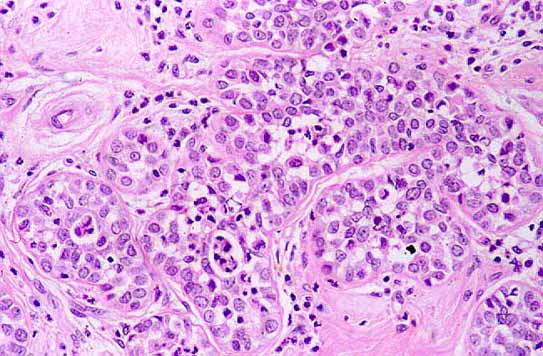
fig. 5

ComunicaciÛn
N∫ 032
ComunicaciÛn |
J. Gonz·lez GarcÌa, M. GarcÌa Rojo, F. MartÌn D·vila, R. LÛpez PÈrez, M. Delgado Portela, A. Puig Rull·n y M. Carbajo Vicente
|
| Foto 5: la celularidad mostraba pÈrdida de cohesividad. |
 |
| Foto 6: Focos de carcinoma lobular in situ en gl·ndula mamaria adyacente al fibroadenoma. |
 |
| Foto 7: detalle a mayor aumento de la afectaciÛn del lÛbulo mamario por carcinoma lobular. |